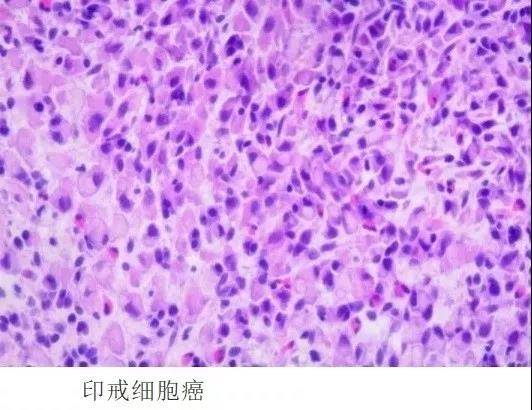
1576638647776049.jpg 24.jpg

胃癌病理基础知识大盘点
作者:杨家龙
库尔勒市第一人民医院消化科
一
胃壁的正常组织结构
胃壁分为四层:黏膜层、黏膜下层、肌层和浆膜层。

图1 胃壁分层示意图
1. 黏膜层由单层柱状上皮(表面上皮和小凹上皮)、固有膜(又称固有层)和黏膜肌所构成。黏膜层厚度为0.3~1.5mm,窦部最厚。
柱状上皮细胞浆内充满中性黏原颗粒,HE染色呈透明状,PAS染色呈玫瑰红色。固有层内有大量的腺体及疏松结缔组织等。

图2 胃上皮层病理示意图
黏膜肌分为内环和外纵两层,在贲门和幽门环处增厚且排列不规则。
2.黏膜下层为疏松结缔组织,内含血管、淋巴管、黏膜下神经丛等;
3.肌层由三层平滑肌组成。内层为斜行肌,中层为环行肌,最外层为纵行肌。环行肌在幽门处增厚,形成幽门括约肌,贲门处环行肌不如幽门括约肌发达。
4.浆膜层由薄层疏松结缔组织及其表面被覆的闰管上皮细胞所构成,间皮下结缔组织中有丰富的淋巴管。
二
胃腺体分类
根据部位及功能,腺体分为贲门腺、胃体腺(又称胃底腺)和幽门腺三种。

图3 胃腺体示意图
贲门腺分布于贲门部,主要由黏液细胞组成,可混有少数壁细胞,腺体为单管状或分支管状,少数腺管轻度扩张,小凹的长度约占小凹和腺体总长度的1/2。

图4 贲门腺示意图
胃体腺分布于胃底和胃体部,由分泌盐酸的壁细胞和分泌胃蛋白酶原的主细胞所组成。腺体为单管状或分支管状,分为颈、体和底三部分:腺颈部上与小凹上皮底相连,壁细胞多分布在腺体部,此段最长,主细胞主要分布在腺底部,小凹的长度约占小凹和腺体总长度的1/4。需要强调的是腺颈部虽短,却含有胃上皮干细胞,因此在胃上皮更新、损伤修复、腺细胞再生及上皮细胞癌变等过程中起着极为重要的作用。


图5、图6 胃体腺示意图
幽门腺分布于胃窦部,由黏液腺组成,为分支管状腺,小凹的长度约占小凹和腺体总长度的1/2。

图7 幽门腺示意图
移行部的腺体由幽门腺和胃体腺所组成,两种腺体交替分布,位于胃窦和胃体交界区域,小凹的长度约占小凹和腺体总长度的1/2。腺上皮细胞之间夹杂着少数不同种类的内分泌细胞:G细胞、ECL细胞等,HE染色不易辨认。

图8 移行部示意图
三
放大内镜下胃黏膜形态与病理对照
应用NBI放大胃镜技术观察正常胃底腺可见到五角形或六角形等形态的毛细血管相互融合成的蜂窝状上皮下毛细血管网(SECN)并向集合小静脉(CV)汇集。表面微细结构:白色半透明的类圆形隐窝边缘上皮(MCE)、茶褐色类圆形的隐窝开口(CO)等。隐窝与隐窝之间称为隐窝间部(IP)。多角形的毛细血管常围绕在隐窝开口周围,呈现规则一致的几何形排列。

图9 胃体腺黏膜形态
正常胃幽门腺黏膜的微小血管结构:由于CV位置更深,表面不易观察到,只能看到均匀的线圈状毛细血管网。表面微细结构:多角形及至弧形的隐窝边缘上皮形成隐窝间结构。隐窝边缘上皮围绕而成的隐窝间的上皮下可见毛细血管,且呈均匀规则的几何形排列。

图10 幽门腺黏膜形态
结合NBI放大内镜正常胃黏膜形态与放大200~400倍病理对照,不仅可清晰观察到隐窝边缘上皮,还可看到柱状细胞规则排列在基底侧。

图11 胃黏膜形态病理对照
四
胃癌癌前病变
① Lauren分型
1965年,lauren根据胃癌的组织形态结构和生物学特征,将胃癌分为肠型、弥漫型和混合型。肠型胃癌常发生于肠化生的基础上,有腺管形成的分化型癌,基本病理过程为:慢性胃炎→胃上皮萎缩→肠上皮化生→异型增生→癌变;弥漫型胃癌起源于胃固有黏膜,组织学基础类型印戒细胞癌,即未分化型癌;混合型胃癌是指肠型和弥漫型成分比例近似。临床多见肠型胃癌,其次为弥漫型胃癌、混合型胃癌。
② 癌前病变路径

图12 癌前病变路径
A.慢性浅表性胃炎(生理性):黏膜表面上皮及小凹上皮有黏液柱状上皮组成,幽门腺由黏液细胞构成,胞核呈椭圆形,规则排列基底侧。
B.慢性浅表性胃炎(幽门螺杆菌阳性):固有层内可见大量炎细胞浸润。
C.慢性萎缩性胃炎:固有层内少量炎细胞浸润,腺体明显减少。
D.肠上皮化生:固有层内腺体见肠上皮化生并伴少量炎细胞浸润。
③ 常见病理术语知识
在病理报告中经常可以看到的三个术语:不典型增生、异型增生和上皮内瘤变,三者的关系及区别(表1)。
表1 不典型增生、异型增生和上皮内瘤变关系及区别

在2010版消化系统肿瘤WHO分类中指出对于不典型性增生这一诊断术语,由于缺乏共识,而且容易导致临床医师误解,因此在消化道、肝、胆管和胰的病理诊断中应避免使用,在消化道,对那些可疑但尚不构成肿瘤诊断的病变,应使用名词“具有不确定的异型增生(上皮内瘤变)”,而非“不典型增生”。
上皮内瘤变按异形程度分为低级别上皮内瘤变和高级别上皮内瘤变;低级别上皮内瘤变指:表现轻微的结构紊乱,只有轻至中度细胞异型。细胞核伸长、有极向、位于基底部,有轻到中度核分裂活性。高级别上皮内瘤变:构成肿瘤的细胞通常呈立方形而不是柱状的,核浆比例高,有更明显的结构紊乱和更多的核分裂。重要的是,细胞核通常延伸到细胞的腔面,核的极向通常丢失。

图13 异型增生与上皮内瘤变对应关系
五
WHO标准与日本标准差异
一直以来,日本和欧美国家的病理医师在早期胃癌的病理诊断标准上存在争议。日本学者认为只要有一定程度的细胞异形和结构异形(如:腺体的密集出芽、复杂分支、融合、筛状结构,黏膜深部腺管横向扩张生长)即可诊断癌,而不依赖肿瘤的位置及浸润深度,欧美国家病理医师认为,肿瘤细胞突破上皮基底膜,浸润至固有层(固有层内可见呈单个或巢状的肿瘤细胞团,常伴间质反应)才是诊断癌的前提。

图14 欧美标准癌的浸润

图15 日本标准异形癌腺管
两者相比,欧美标准依据浸润作为癌的客观证据,严格界定癌的定义,可避免临床上过度治疗,但存在一定缺陷:①胃活检取材较小且表浅不易找到浸润证据;②临床医师可能低估上皮内瘤变的危险性;③阻碍病理医师对黏膜内癌和高级别上皮内瘤变的鉴别的能力;④活检标本与手术切除标本的病理诊断结果不一致。而影响临床治疗方案的选择和对患者预后的评估。
日本病理医师常常把欧美病理医师认为的上皮内瘤变诊断为非浸润性黏膜内癌,且这一标准的诊断与ESD或手术切除标本的病理诊断结果有较好的一致性,即部分被日本病理医师在胃黏膜活检时诊断为癌的病例,手术或ESD标本证实为早期胃癌或进展期癌。这可也解释了为何相比于其他国家,日本早期胃癌检出率较高。
对于胃活检日本和WHO都给出了分类标准,两者对应关系如下:

需要特别指出的是WHO标准中的“腺瘤”是指肉眼形态为隆起型的上皮内瘤变,分为肠型腺瘤与胃型腺瘤,胃型腺瘤又分为幽门腺型和小凹型。日本分类中的腺瘤是指良性的上皮内肿瘤,可以是任何肉眼形态(隆起、平坦、凹陷),可划分成肠型腺瘤及胃型腺瘤;肠型腺瘤对应WHO分类的肠型(腺瘤型)上皮内瘤变(异型增生)的一部分,胃型腺瘤对应WHO分类中的幽门腺腺瘤。
自从WHO维也纳分类制定以后,我国病理医师依照WHO定义消化管上皮癌前病变并广泛应用于临床,随着内镜设备的更新及内镜技术的发展,许多消化道早癌结合放大内镜便可以给出准确的诊断,而在内镜诊断上我国受同为亚洲国家的日本影响,多采用日本诊断标准,因标准差异导致病理与内镜诊断脱轨,镜下诊断与病理诊断不符而无法进一步指导治疗,作为一名临床医生必须理解两者之间的差异,也正是基于病理诊断差异,我国在制定胃癌诊疗规范(2018年版)中明确指出部分活检病理低级别上皮内瘤变可内镜下切除。

图16 选自胃癌诊疗规范(2018年版)胃癌精查和随访流程
六
胃癌病理特点
胃癌病理特点往往从异形细胞、异形腺体以及表层细胞缺乏分化成熟等特点判断,但部分胃黏膜活检病理诊断中区别高级别上皮内瘤变和癌比较困难。可以通过腺管结构异常鉴别分化型胃癌或者高级别瘤变,如分化型腺癌往往存在无限延长、成角腺管等特殊的腺管形态及出现腺管的异常融合(正常胃腺体排列规则,分支呈倒Y型。而分化型腺癌,腺体可呈W、H、X 及正Y型融合。)等。


图17、18 癌腺管异形融合

图17、18、19 癌腺管异形融合
依据特殊腺管形态形成的结构异型诊断癌可有以下优点:
(1)结构异型不发现于正常黏膜,且低倍镜下就可观察到;
(2)比细胞异型性(核异型)更加客观;
(3)是低度细胞异型性高分化腺癌的有力诊断线索。
Takahashi和Iwama发现胃高分化腺癌腺管彼此融合是腺癌早期浸润性生长的一种方式。此外,圆形扩张腺管中坏死碎片的存在(即内镜下观察到的白色球状物WGA)也可能成为诊断胃癌的依据之一。
七
胃癌分类
胃癌中绝大部分为腺癌,依照WHO胃肿瘤组织学分类常见的胃癌组织学类型有管状腺癌、乳头状腺癌、低粘附性癌(包括印戒细胞癌和其他亚型)、黏液腺癌、混合型腺癌。
1. 管状腺癌多发生于慢性萎缩性胃炎及异型增生的基础上,癌细胞形成管状结构,根据分化程度可进一步分为高分化、中分化和低分化管状腺癌。

图20、21 管状腺癌病理示意图
2. 乳头状腺癌好发于贲门部,肿瘤组织呈乳头状结构;有时部分扩张的肿瘤性管腔内肿瘤组织呈乳头状生长,诊断为乳头状管状腺癌。

图22 乳头状腺癌病理图
3. 印戒细胞癌多发生于年轻女性患者的胃体腺分布区域,癌细胞单个或片状分布,不形成管状结构,癌细胞呈圆形或卵圆形,胞浆内黏液丰富,大量的黏液可将细胞核压向一侧,整个细胞形似印戒。
图23 印戒细胞癌病理图
4. 黏液腺癌中癌细胞产生大量黏液,并将黏液分泌到细胞外,形成“黏液湖”,癌细胞可从管壁脱落漂浮于其中。
5. 混合型腺癌,胃腺癌组织在发病的早期多为一种组织学类型,但随着疾病的发展,肿瘤细胞不断分裂增生,可发生表型的改变,表现为两种或多种组织学类型,称为混合型腺癌。

图24 胃黏液腺癌、混合型癌病理图
参考文献:
1.胃癌诊疗规范(2018年版)
2.消化系统肿瘤WHO分类
3.上消化道活检组织病理学 金珠
4.食道和胃病理学图谱 斯科特.R.欧文斯亨利.D.艾佩尔曼著
5.拡大内視鏡による胃炎,腺腫,胃癌の鑑別診断 土山 寿志
6.胃肠病理学 芬诺格利奥-普赖瑟
7.消化道病理学 纪小龙
收藏
回复(3)参与评论
评论列表






